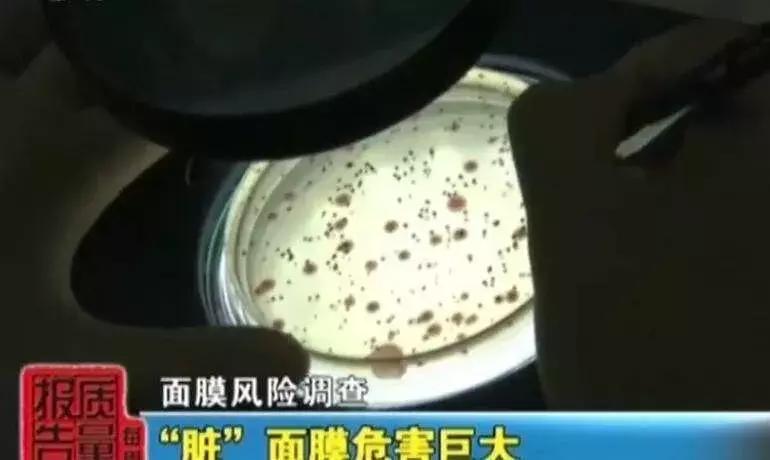
奇点315最新,315各行业被曝乱象内幕

又是一年3·15,不论是假货问题频出的电商平台,还是发生过安全事故的商业品牌,以及安全事故频发的购物中心,奇点君这篇盘点都旨在为行业带来一点“冷思考”。
又到了一年一度的3·15国际消费者权益日,中消协今年发布的消费维权主题是“信用让消费更放心”。呼吁加快消费领域信用体系建设、倡导经营者依法诚信经营、鼓励引导消费者依法主张自身权益。
正如中消协所说,如今我们的消费环境越来越好,但同时消费维权环境也变得更为复杂。回首近年发生的消费安全事件,诚信缺失、监管失责、防范意识薄弱是问题多发的主要原因。
不可否认,偶然发生的消费安全事故是小概率事件,但对于“中招”的消费者来说却是100%的伤害,尤其是那些危害生命安全的事故,不但给当事人及其家人带来不可估量的伤害,也是当事企业社会责任感的缺失。
3·15对于消费行业和商业领域而言,是一个非常重要的时间节点,凤凰网奇点商业出品3·15行业调查,不仅囊括假货问题频出的电商平台,发生过安全事故的商业品牌,也盘点了安全事故频发的购物中心,旨在为行业带来一点“冷思考”。
电商
投诉高速增长,平台表现参差
网上购物方便快捷,商品价格低廉,如今越来越多的时尚消费者加入网购行列。数据显示:截至2018年12月,我国网络购物用户规模已达6.10亿,年增长率为14.4%。如此庞大的消费群体,消费者权益保障如何到位?
今年3·15恰逢《电子商务法》实施后的首个消费者权益日,经社-电子商务研究中心发布的《2018年度中国电子商务用户体验与投诉监测报告》披露了“2018年度零售电商十大热点被投诉问题”,分别为退款问题、商品质量问题、发货问题、霸王条款、虚假促销、网络售假、退店保证金难退还、退换货难、客户服务、物流问题。
在“2018年全国零售电商TOP30消费评级榜”上,依据平台反馈率、反馈时效、满意度等多项评估指标,好乐买、闪电降价、萌店、猎趣等7家零售电商平台用户综合指数低于0.4,获“不建议下单”的购买评级。

跨境电商方面,小红书、洋码头因用户满意度综合指数相对较低,获“谨慎下单”购买评级。
电子商务研究中心法律权益部助理分析师蒙慧欣表示,跨境网购消费纠纷频现的重要原因之一是消费者认知问题,很多消费者刚开始接触跨境网购,对于跨境网购不能提供国内意义上的发票,且难以判断商品的真假,导致很多商家以提供正规发票等问题诱导消费,产生系列消费问题。
餐饮业
外婆家等品牌上黑榜 消费者选择更谨慎
当前,随着经济的快速发展与互联网变革,我国餐饮市场竞争也在发生巨大变化。调查显示,2018年全国餐饮收入42716亿元,同比增长9.5%。
食品安全问题作为餐饮品牌生存的红线,一旦触碰必然降低消费者的信任度与忠诚度,不仅名誉受损,还将面临闭店风险。
今年3.15上,又有餐饮企业上黑榜,而且还是曾经领跑餐饮行业转型的标志性品牌——外婆家。

3月15日,荔直播公布了一段*底卧**外婆家某家旗下某家门店的后厨视频,视频中该门店后厨工作人员在洗菜池洗拖布,不洗菜直接炒,还有很多厨师和工作人员直接踩踏案板,甚至还有工作人员会通过给过期食材更换生产时间的方式蒙混检查。外婆家创始人吴国平回应称会对涉事门店进行停业整顿。

而日前,海口的张亮麻辣烫也因出售三无的“复合肉卷”被停业整顿。
回顾近两年来出现过食品安全事件的品牌:一笼小确幸 “腹泻门”事件、味千拉面“骨汤门”泥淖、海底捞被爆“老鼠乱窜、使用地沟油”等严重卫生问题,这一幕幕令消费者至今心有余悸。
置顾客利益于不顾,明星开的店也难顺利经营。
刚刚过去的一年,杜海涛餐厅引发7人腹泻、李晨餐馆被吐槽“一碗没有肉的面三十块”、黄磊和孟非合开的"黄粱一孟"火锅店也因价格过高闭店。
有业内人士指出,餐饮行业迅速发展的同时,一些商家相关的系统审查、标准化操作等并没有跟上。而消费者选择也日趋理性,不再只为品牌效应买单,而是更加关注商品本身质量,性价比高的才会成为他们的最终选择。
美妆行业
多家知名品牌质检不合格
值即正义的档口,化妆品市场也呈现高速扩张态势,消费者对化妆品日益增长的需求促使行业内品牌和企业数量的增加,同时不法商家也盯上了这块蛋糕。
从近年查处的数桩“进口美妆假货案”中可以一窥,当前化妆品代购乱象丛生。
为使消费者相信产品的“海外血统”,竟有人将假货运到国外再通过代购回邮;更有甚者团伙作案,从网上回收真的化妆品瓶子后,在不到二十平方米的房间内完成“人工清洗-印刷包装-分瓶灌装”的网红高档化妆品制假“一条龙”操作。

此外,投入100万“研发”正品包装、品牌“内贼”与不法分子串通“泄露”喷码、假冒品流通端 网店-代购-实体 “见缝插针”等手段更是令人瞠目。
假冒盛行之外,不少知名品牌本身存在造假、品质不合格等问题。
2018年9月26日,某美妆博主在微博发文称,已对雅诗兰黛旗下品牌LAMER(海蓝之谜)提起诉讼,原因是其虚假宣传并不存在的修复疤痕功效,lamer欺骗中国消费者购买,而且仅在中国虚假宣传,该行为已严重违反我国广告法。
在去年国家药监局公布的1071批次检验不合格的化妆品中,自然堂防晒乳液、日本安耐晒防晒露、森田面膜、施华蔻怡然染发霜等知名品牌榜上有名。
随着各大电商平台加码美妆领域,国家层面加速保税区建设,消费者对化妆品及进口美妆的需求与日俱增,选择渠道日益丰富,提高防范意识谨防受骗已成必备素养,而在这场流量争夺战中,化妆品品牌商家如何修炼自身、加强仿冒监管更应提上重要议程。
购物中心
安全管控缺位,谁为生命买单?
近年来,国内多座知名购物中心发生不同性质、不同程度的安全事故。轻则让消费者虚惊一场,重则造成人员伤亡,带来极为恶劣的社会影响。
说到安全事故拼出的购物中心,很多人第一个想到的就是大悦城。
2018年2月11日13时许,北京西单大悦城商场内一名男子持械行凶,现场12人受伤,1名女性因抢救无效死亡。相信很多人对这一事件还心有余悸。
然而,这已经不是大悦城第一次出现安全事故,2017年,天津大悦城发生“人间惨剧”,一个爸爸抱着两个孩子站在商场四楼的护栏边,两个孩子不幸双双坠楼身亡。
而朝阳大悦城更是事故多发区,有媒体统计,其自2010年10月开业以来,至少发生了9起事故。
2014年11月,朝阳大悦城墙面装饰板被大风吹落,砸中两名过往行人,一人当场死亡,一人腰部受伤。
2013年10月27日,一名30多岁的男子在朝阳大悦城的第5层电梯处坠楼身亡,坠落地点正好在大悦城门口。
2013年3月9日,一名男子从大长滚梯上跳下去,当场死亡。
2011年7月28日,朝阳大悦城一部观光电梯向下运行时,突然停在5层和4层之间,电梯中18名顾客被困。
除了大悦城,上海的新城吾悦广场也发生过严重的安全事故。2016年11月11日,一名仅4个月大的男婴不慎从3楼高度的自动扶梯上坠落,抢救无效死亡。
电梯绞住顾客衣服或鞋子的“咬人事件”时常见诸新闻,老牌百货王府井也难逃安全事故“魔咒”。
2017年5月,长沙市民温女士一家三口在河西王府井商场逛街,五岁大儿子右脚的鞋子被扶手梯虎口的缝隙卡住。

如果站在购物中心的角度分析以上安全事件,大致可将其分为两类,即负有直接责任的和负有间接责任。一般来说,前者对购物中心的负面影响更大,购物中心因承担责任而增加的经济成本也更大。
但不论如何,作为人流量很大的公共场所,购物中心都应该做好充分准备和安全措施,以应对各类突发事件。尤其像大悦城这样的知名央企,如果不能为消费者提供一个安全的消费场所,把控基本的底线,一切在行业中取得的成就都黯然失色,又何谈社会责任与担当?
今年的315晚会,不知是否又会有我们熟知的品牌上榜,曝光不是目的,我们真诚希望,广大商家能够更加考虑到对消费者的权益保护,真正站在消费者的角度把握细节,构建更加绿色、安全、和谐的商业消费生态圈。
奇点商业地产原创
转载请联系并注明来源

奇点 · 新媒体矩阵
头条号丨大风号丨百家号
大鱼号丨一点号丨企鹅号